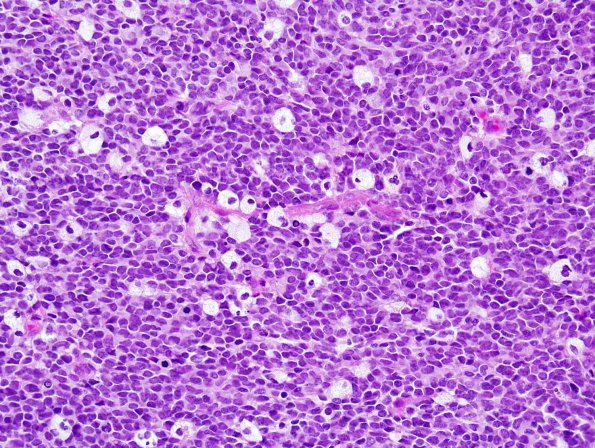
11B1 ATRT (Case 11) H&E 7.jpg

Table of Contents
Washington University Experience | NEOPLASMS (EMBRYONAL) | ATRT - Atypical Teratoid Rhabdoid Tumor | 11B1 ATRT (Case 11) H&E 7.jpg
11B1-5 Sections of the "right frontal mass," reveal a highly cellular, primitive-appearing neoplasm with nuclear pleomorphism. The majority of tumor cells have oval to irregular hyperchromatic nuclei with minimal discernible cytoplasm. However, larger more pleomorphic cells are also seen. The mitotic index is brisk and there are numerous pyknotic cells. Rhabdoid cells (11B5), necrosis and nuclear molding are prominent. (H&E)